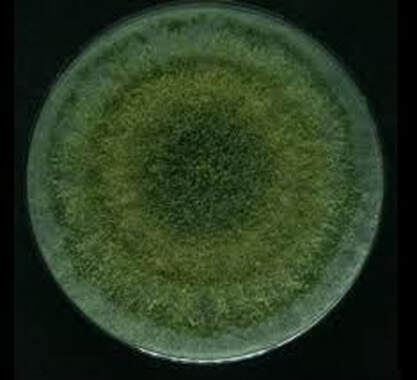

Trichoderma: Biological control for Ganoderma

Trichoderma will protect the roots from being infected by the previous stand’s root fragments by destroying them on contact.
Trichoderma also strengthen’s the palms own defense mechanisms.
Trichoderma releases metabolites that promote more vigorous root and vegetative growth.
Trichoderma will remediate the poor soil condition in and around the rhizosphere. It helps break down chemical pesticides residues in the soil.
Trichoderma also strengthen’s the palms own defense mechanisms.
Trichoderma releases metabolites that promote more vigorous root and vegetative growth.
Trichoderma will remediate the poor soil condition in and around the rhizosphere. It helps break down chemical pesticides residues in the soil.